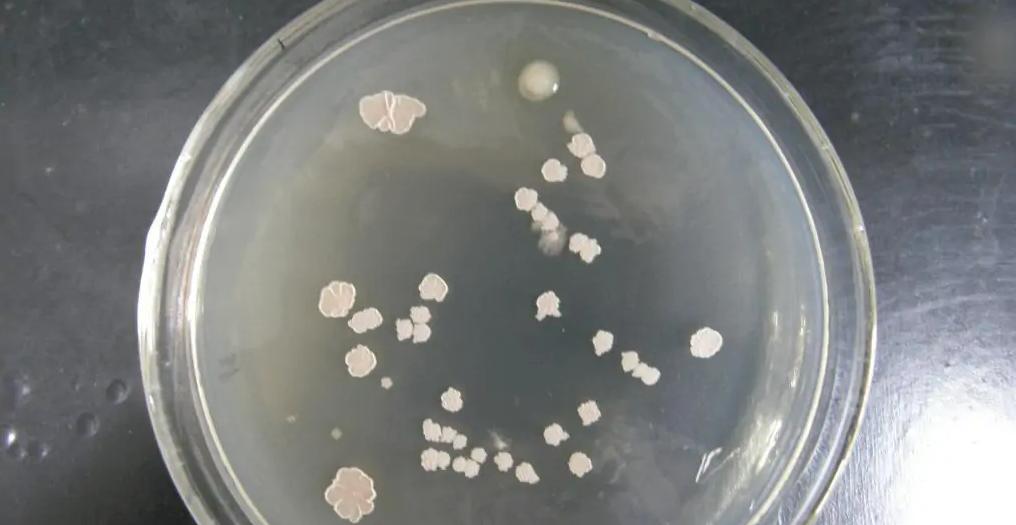
水产养殖芽孢菌分几种,水产芽孢杆菌分类

在水产养殖中,芽孢杆菌是一类非常常见水产用菌,是严格需氧或兼厌氧的有荚膜杆菌,芽孢杆菌的重要特性是能够产生对不利条件具有特殊抵抗力的芽孢。
所以,芽孢杆菌很多的下分的亚群菌属,往往因各种用途而被广泛用于水产养殖。

这里我们列举了常见的4种芽孢杆菌,来看看每种的作用和区别:
【1】地衣芽孢杆菌;
地衣芽孢杆菌细胞形态和排列呈杆状、单生,可调整菌群失调达到治疗目的,可促使机体产生抗菌活性物质、杀灭致病菌,能产生抗活性物质,并具有独特的生物夺氧作用机制,能抑制致病菌的生长繁殖。
适用于细菌原因引起的肠道菌群失调症以及肠道需要保健的养殖动物。
【具体作用】
1、具备抑制有害病菌的发生,提高水产养殖物的集体免疫功能,同时调节微生态平衡;
2、能够降解水体中氨氮这类有毒物质,并有效降低池塘水体的耗氧量;
3、能够促进养殖物的生长,提升饲料利用率;
【2】枯草芽孢杆菌;
枯草芽孢杆菌生长速度快,对营养要求比较低,能高效分泌许多蛋白及代谢产物,且其不会产生毒素,是一种无致病性的安全微生物,广泛分布在土壤及腐败的有机物中, 易在枯草浸汁中繁殖而得名。
【具体作用】
1、枯草芽孢杆菌可以在动物组织表面或植物体内及植物生长的土壤中快速、大量繁衍和定植,有效地阻止病原微生物的繁殖,如弧菌、大肠杆菌等;
2、净化水质,枯草芽孢杆菌对于池塘水体中的残饵剩料以及水产养殖物的排泄物和塘底沉淀的有机物质都有非常好的分解效果,从而起到净化水质的作用;
3、枯草芽孢杆菌可以吸附在病原真菌的菌丝上,伴随菌丝共同生长,生长过程中会产生溶菌物质,从而消解菌丝体;
4、能够抑制蓝藻等有害藻类的繁殖;
5、枯草芽孢杆菌具体较强的蛋白酶、脂肪酶的活性,能够促使水产养殖生物对饲料的利用率增强。
【3】凝结芽孢杆菌;
在水产养殖的使用中凝结芽孢杆菌是兼厌氧菌,在有氧及无氧的环境下都可生长,能适应低氧的肠道环境,对酸和胆汁有较高的耐受性,能够进行乳酸发酵,产生的L-乳酸能降低肠道PH值,抑制有害菌。
但和其他的益生菌有所不同的是,凝结芽孢杆菌在肠道上皮细胞的粘附性较弱,所以在自然条件下一般很难在肠道中存在,因此,作为肠道内的“移民”,凝结芽孢杆菌只能在肠道内做短暂的停留,一次性内服凝结芽孢杆菌后,经过大约4~7天时间肠道内的凝结芽孢杆菌便会通过排便而消失殆尽。
所以只有持续服用凝结芽孢杆菌菌剂,才能使得该菌在肠道中充分发挥其益生作用。
【具体作用】
1、调节水产养殖物的肠道微生态菌群平衡,促进强化肠道消化功能;
2、能够产生L-乳酸能降低肠道PH值,抑制有害菌;
3、能够抑制池塘内有毒物质的产生,规避水体富营养化的问题,促进水质净化,减少养殖物病害出现的几率。

【4】复合芽孢杆菌;
复合芽孢杆菌本身就具备枯草芽孢杆菌、纳豆芽孢杆菌、地衣芽孢杆菌、腊状芽孢杆菌及生物酶、维生素、微量元素等辅助剂,能够在短期内繁殖成高含菌量的优势种群,消耗掉肠道内大量氧气,并能产生过氧化氢、细菌素,建立微生态平衡,促进有益厌氧微生物的繁殖,抑制有害细菌(大肠杆菌、沙门氏杆菌)的生长。
【具体作用】
1、能降解植物性饲料中复杂的有机物,从而促进消化吸收,提高饲料利用率,防止动物消化不良,出现“饲料便”等状况发生;
2、能够有效抑制有害菌滋生,对老水、黑水、红水等水质有调节作用;
3、能够降解池塘中的残饵剩料,对于塘底沉淀的有机物质也具备分解、降解效果,能够消除水体异味。
本文图片源自网络,侵删~